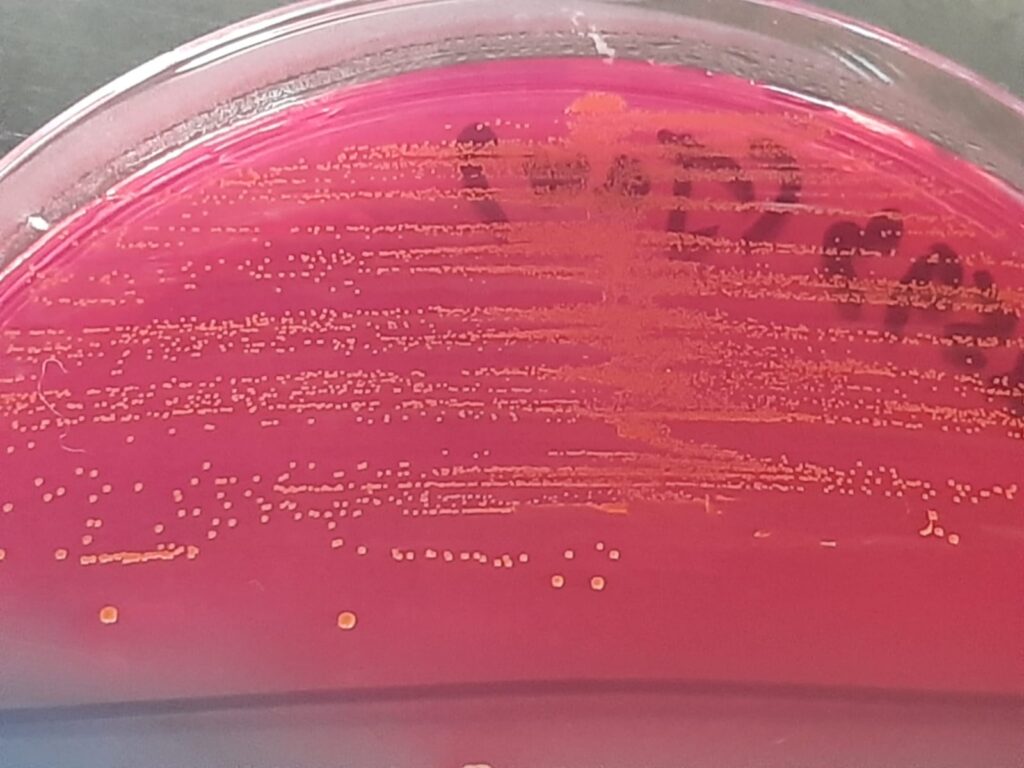
Lactococcus- Introduction, Pathogenicity, Lab Diagnosis, Treatment, Prevention, and Keynotes

Lactococcus is a genus of Gram-positive, catalase-negative, non-spore-forming cocci, usually arranged in pairs or short chains. They are facultative anaerobes and are best known for their beneficial role in dairy fermentation (e.g., cheese and buttermilk production). Although generally regarded as low-virulence organisms, Lactococcus species can act as opportunistic pathogens, especially in immunocompromised individuals.
Normally part of food-associated and environmental microbiota
Opportunistic infections reported in:
Immunocompromised patients
Elderly individuals
Patients with valvular heart disease, malignancy, or indwelling devices
Reported clinical conditions:
Bacteremia
Infective endocarditis
Urinary tract infections
Wound and soft tissue infections
Virulence is low, and disease often results from host factors rather than aggressive bacterial toxins
Blood, urine, wound swab, body fluids (depending on infection site)
Gram stain: Gram-positive cocci in pairs or short chains
Catalase test: Negative (helps differentiate from Staphylococcus)
Growth on Blood agar: small, grayish, non-hemolytic or α-hemolytic colonies
Growth on SDA is possible (acid-tolerant), sometimes mistaken for yeasts/bacteria mix
Does not grow well in high salt (unlike Enterococcus)
PYR: usually negative
Bile esculin: negative
Sugar fermentation tests may assist
MALDI-TOF MS (preferred)
16S rRNA sequencing (confirmatory)
Most isolates are susceptible to beta-lactam antibiotics
Commonly effective drugs:
Penicillin
Ampicillin
Amoxicillin
Ceftriaxone
Severe infections (e.g., endocarditis):
Beta-lactam ± gentamicin (based on susceptibility)
Always perform antimicrobial susceptibility testing (AST) due to variable resistance
Good food hygiene and handling practices
Proper care of indwelling catheters and medical devices
Early identification and treatment in high-risk patients
Strict aseptic techniques in clinical settings
Gram-positive, catalase-negative cocci
Commonly misidentified as Streptococcus or Enterococcus
Opportunistic pathogen with low intrinsic virulence
Increasingly detected due to MALDI-TOF and molecular methods
Clinical relevance depends on the host’s immune status